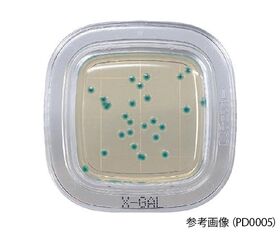

説明
【特徴】
●ぺたんと押して微生物チェックします。
●特定の汚染菌の有無を選択的に確認できます。
●一般細菌検出用培地は最短8時間で判定が可能です(発色液を使用)。
【仕様】
●品名:X-GAL寒天培地
●使用目的:大腸菌群検出用
●測定する集落:青色又は青緑色の集落
●入数:1箱(20枚入)
●培地表面積:10cm2
●有効期限:4ヶ月
追加情報
メーカー名:
栄研化学
メーカー品番:
PD0005
予定納期:
通常3~5日で発送予定